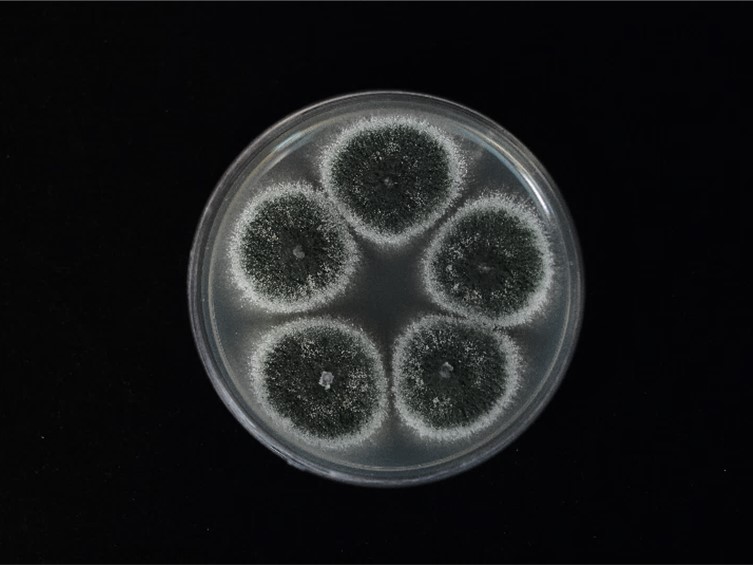

Holotype:
THAILAND, Chaiyaphum Province, Phu Khiao Wildlife Sanctuary, 24 Oct. 2007, K. Tasanathai, S. Mongkolsamrit, P. Srikitikulchai, B. Thongnuch, R. Ridkaew, A. Khonsanit, holotype BBH 22698, ex-type living culture BCC 28246.
Habitat:
Underside of dicotyledonous leaves.
Host:
Moth (Lepidoptera), Barklice (Psocoptera).
Description:
 Host covered with pale green mycelium and sporulating conidiophores.
Host covered with pale green mycelium and sporulating conidiophores.  Conidia smooth-walled, parrot green, broadly fusoid, 5-6 × 2-3 μm.
Conidia smooth-walled, parrot green, broadly fusoid, 5-6 × 2-3 μm.
Culture characteristics:
Colonies on PDA attaining a diam of 22 mm in 14 d, dark green, flat, entire edge, white border, dark green of colonies due to production of conidia. Sporulation starts at 5 d after inoculation, reverse uncoloured. Conidiophores terminating in branches, with 2–3 phialides per branch. Phialides cylindrical with semipapillate apices, 5–10 × 2–3 μm. Conidia smooth-walled, parrot-green, ellipsoidal to cylindrical with rounded apices, 5–10 × 2–3 μm.
Colonies on PDA attaining a diam of 22 mm in 14 d, dark green, flat, entire edge, white border, dark green of colonies due to production of conidia. Sporulation starts at 5 d after inoculation, reverse uncoloured. Conidiophores terminating in branches, with 2–3 phialides per branch. Phialides cylindrical with semipapillate apices, 5–10 × 2–3 μm. Conidia smooth-walled, parrot-green, ellipsoidal to cylindrical with rounded apices, 5–10 × 2–3 μm.
Reference:
Mongkolsamrit S, Khonsanit A, Thanakitpipattana D, et al. (2020). Revisiting Metarhizium and the description of new species from Thailand. Studies in Mycology 95: 171–251.
DOI: https://doi.org/10.1016/j.simyco.2020.04.001Species |
Strain |
Compound |
Pubchem CID |
Biological activity |
Reference |
|---|
|
Strain |
ITS | LSU | RPB1 | RPB2 | SSU | TEF1 |
|---|---|---|---|---|---|---|
| BCC 28246 | MN781893 | MN781844 | MN781749 | MN781796 | MN781944 | MN781699 |
| BCC 41242 | MN781894 | MN781825 | - | MN781780 | MN781942 | MN781679 |
| BCC 53130 | MN781843 | - | MN781795 | MN781943 | MN781698 |